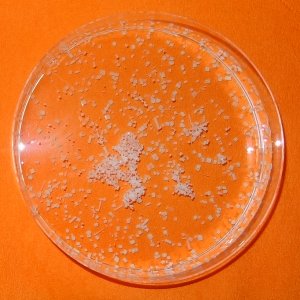

|
Experiment des Monats
|
Kochsalz kristallisiert in Würfeln ... aber nicht immer ...
|
 |
 |
Geräte und Chemikalien:
Natriumchlorid,
Harnstoff,
Petrischalen, Bechergläser, Spatel.
Durchführung:
Zuerst bereitet man eine gesättigte Kochsalz-Lösung.
Eine Petrischale ca. 5 mm hoch mit der Kochsalzlösung füllen.
In einer zweiten Probe der Lösung zwei Spatel Harnstoff auflösen und in eine
zweite Schale füllen. Nach mehreren Stunden (z.B. über Nacht - an einem ruhigen Platz
- stehen lassen) bilden sich in beiden Schalen Kristalle.
In der Vergrößerung erkennt man in der reinen Kochsalz-Lösung nur würfel-
und quaderförmige Kristalle, in der Harnstoff-haltigen Lösung sind teilweise
oktaedrische Kristalle entstanden.
(Auch bei höherer Harnstoff-Konzentration gelang es nicht, ausschließlich
oktaedrische Kristalle zu erhalten.)
Erklärung:
Kochsalz bildet in der Regel Kristalle mit {100} Flächen - also Würfel oder Quader mit rechten Winkeln.
Bei Vorhandensein von Harnstoff entstehen oktaedrische Kristalle mit {111} Flächen, unter Einfluß von
Glycin Rhomben-Dodekaeder mit {110} Flächen. Die dafür verantwortlichen Mechanismen sind noch nicht
aufgeklärt, man vermutet, dass die organischen Moleküle Kanten besetzen und dadurch das abweichende
Kristallwachstum induzieren.
Entsorgung:
Die Lösungen können zum Abwasser gegeben werden
Literatur & Links:
Forschungszentrum für
Historische Geisteswissenschaften der Goethe-Universität
W. Wagner
(Univ. Bayreuth): Züchten von Kristallen
September 2016: Rote Bete Titration
 zurück zum aktuellen Experiment
zurück zum aktuellen Experiment
Seite erstellt am: Freitag, 18. November 2016,
A. Schunk,
Charité - Universitätsmedizin Berlin.
Für den Inhalt externer Seiten wird keine Verantwortung übernommen!